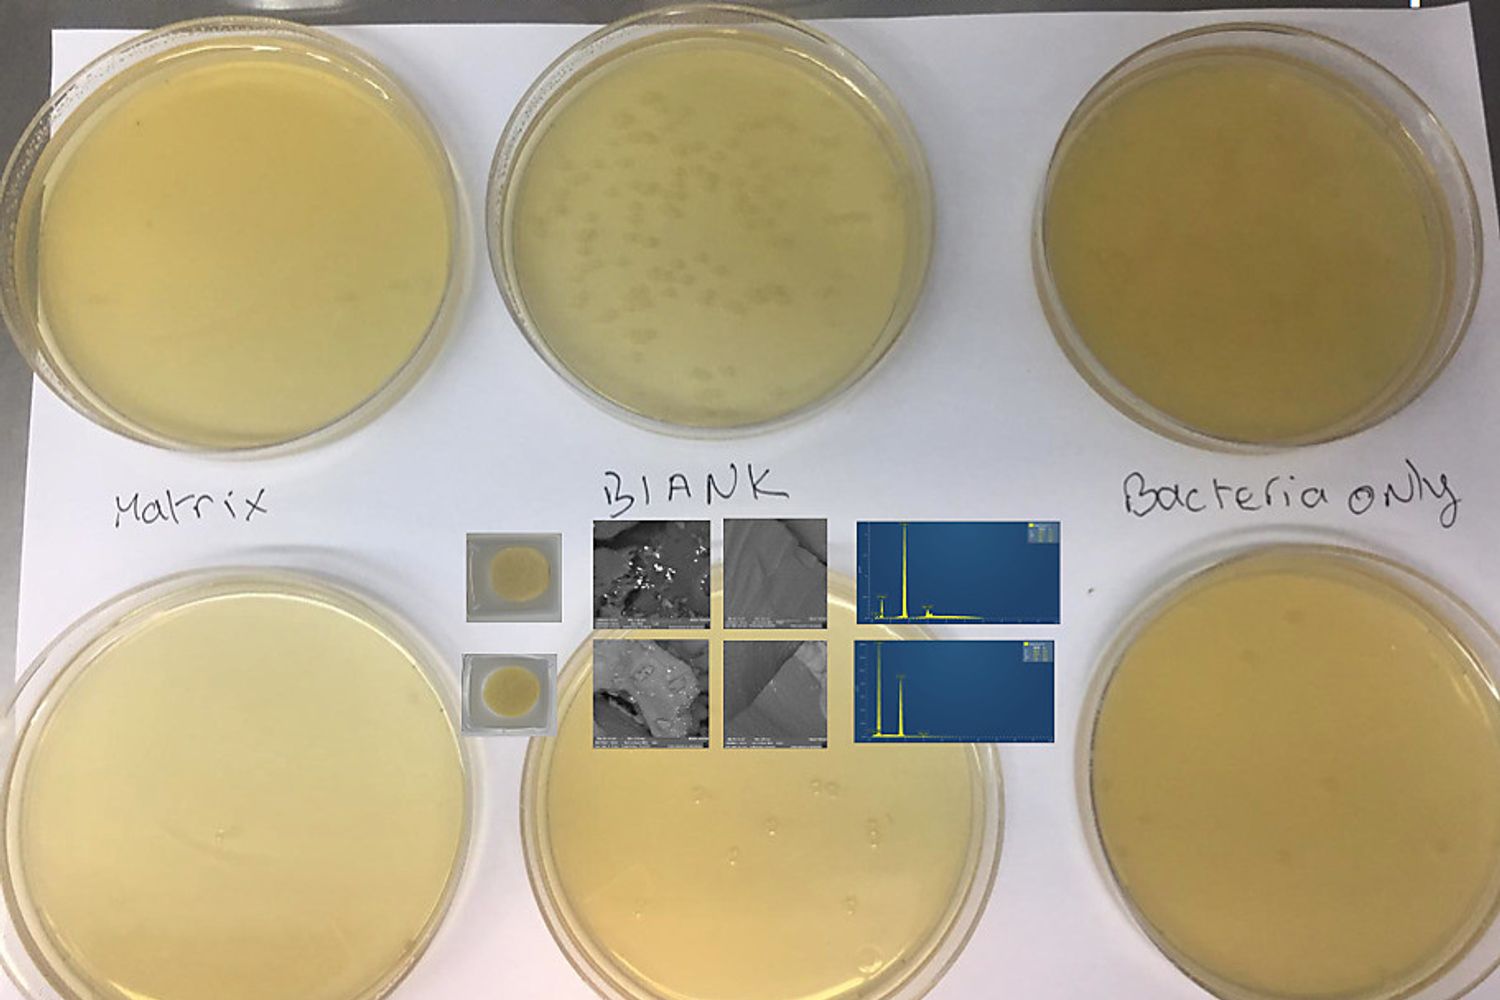
911x684

Il rivestimento in SilverSil per mascherine e camici antivirali

È di pochi giorni fa la bella notizia del lancio di mascherine antibatteriche e antivirali da parte di un’azienda svizzera capaci di contenere anche il coronavirus responsabile dell’infezione virale (e poi anche batterica) nota come Covid-19. A renderle tali, è anche la funzionalizzazione dei tessuti in questione con argento “colloidale”, ovvero con nanoparticelle di argento in soluzione la cui attività antibatterica è nota da oltre due millenni.
Simili straordinarie proprietà antibatteriche ha anche il coating (rivestimento) SilverSil dai noi sviluppato al Cnr in collaborazione con il team di Yael Albo alla Ariel University in Israele. Il materiale, una forma di vetro (silice amorfa) modificato organicamente poi funzionalizzato con nanoparticelle di argento, mostra una potente quanto stabile attività antibatterica nei confronti dei batteri Gram-negativi e Gram-positivi, incluso il patogeno resistente alla meticillina Staphylococcus aureus.
Ciò che poi fa la differenza dal punto di visto applicativo è che il rivestimento “sol-gel” può essere facilmente depositato su qualsiasi tipo di superficie, inclusa quella delle fibre tessili più comuni: cotone, poliestere, acrilico, poliammide etc.
Anche a causa della semplicità del processo di funzionalizzazione delle fibre - che in pratica vengono rivestite con i sottilissimi (pochi micron di spessore) coating in questione tramite semplici tecniche spray o di rapida immersione - sono numerose nel mondo le aziende (una anche nella provincia di Bergamo) che utilizzano simili coating sol-gel per per produrre tessuti idrorepellenti, antistatici, antifiamma, dotati di particolari proprietà ottiche quali la protezione dai raggi ultravioletti e, appunto, antibatterici.
Le nanoparticelle di argento mostrano anche potente attività antivirale nei confronti di numerosi virus. Testeremo a breve con i colleghi israeliani, quando sarà concluso il periodo di confinamento dovuto all’emergenza sanitaria in corso, anche quelle del SilverSil.
È più che verosimile che l’attività antivirale scoperta dai colleghi svizzeri verrà confermata anche per questo coating la cui composizione ed utilizzo come antibatterico per funzionalizzare le più svariate superfici, inclusa quella delle fibre tessili, è stata pubblicata nella letteratura scientifica Open Access, ovvero accessibile a tutti gratuitamente sul web (lo studio sottoposto a peer-review sarà pubblicato fra pochi giorni su ChemistryOpen).
La scoperta è stata deliberatamente mantenuta libera (cioè, non sottoposta a brevetto) per consentire a qualsiasi Paese di produrlo e utilizzarlo liberamente vista l’importanza sanitaria e sociale delle sostanze e dei materiali antibatterici e, speriamo, antivirali.
Le aziende fornitrici delle fibre tessili usate per la produzione accelerata di mascherine e indumenti per la protezione individuale, possono farvi liberamente riferimento per produrre (e testare) fibre funzionalizzate con SilverSil.